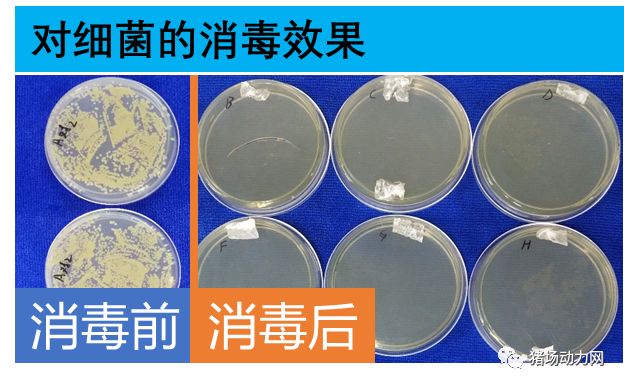
幻影360分子悬浮消毒机消毒原理,幻影360分子悬浮消毒机使用方法

幻影360分子悬浮消毒,空间消毒新方式
让空间真正做到360°无死角消毒

幻影360分子悬浮消毒机采用独家专利技术,使消毒剂和增效剂形成分子喷雾,均匀喷射到空气中,使消毒药能360°无死角覆盖到空间的任何角落,让每一个消毒分子都发挥作用;其专用增效剂能作为载体,主动吸附,协同增效实现彻底消杀,又能增加消毒药分子在空气中的悬浮时间,达到长时间持续消毒的效果。

幻影360分子悬浮消毒机具有开盖即用、协同增效、悬浮持久、节约高效、更少噪音、操作简单、人员轻松等特点,在猪场的栏舍、人员通道、仓库、更衣室等,以及饲料仓库、物资中转站、洗消中心等密闭空间均可应用,而且还适用于带畜禽消毒。
自4月中旬上线以来,就以其分子悬浮消毒-360°无死角空间消杀的概念吸引了行业内人士的极大关注,获得了广大用户的认可和支持。
车辆洗消中心全新解决方案-成本更低,简单高效,使用更便捷
但近期发现市面上有多家单位和个人生产、销售与其专利产品相似的产品(以下简称“相似产品”),该相似产品外观与委托人产品的外观专利高度相似,其宣称的工作原理全部落入幻影360申请的实用新型和发明专利的权利要求范围,其产品使用说明书、宣传资料等文件与幻影360的相关文件内容实质相似。
幻影公司早已就“幻影360分子悬浮消毒机”申请了外观设计、实用新型和发明专利,其中外观专利和实用新型专利已获授权,发明专利已进入实质审查阶段。
再此幻影公司郑重申明,幻影公司没有委托过任何单位和个人生产相关产品,以下为幻影公司委托湖北晴川律师事务所就有关单位和个人未经授权生产、销售仿冒委托人专利产品的商品事宜,发表律师声明。


幻影360分子悬浮消毒三大优势
1.操作简单,使用轻松
开盖即用,无需稀释,直接放上消毒剂和增效剂,一键开启即可,操作简单,告别稀释倍数,杜绝浪费,让每一分消毒药都发挥价值,消毒人员无须来回走动,工作轻松。
2.湿度更低,带畜禽消毒更舒爽
使用360分子悬浮消毒机进行畜禽消毒,对空间湿度、温度、PM2.5都没什么影响,且选用食品级消毒药,对动物健康友好,消毒效果有保障。
3.协同增效,持久悬浮
独创增效剂与消毒剂配套使用,悬浮消毒效果更好更持久,而且弥漫速度快,100m³-10ml药剂,2分钟充满整个空间,快速实现养殖场、饲料厂等密闭、半密闭空间的360°无死角消毒。

幻影360消毒效果经过大量实验验证
幻影360分子悬浮消毒机配合消毒剂及增效剂可以实现对细菌(包括芽孢)、支原体、病毒的有效杀灭,可持续杀毒时间长达5小时。

幻影360客户应用场景


分子悬浮消毒请认准幻影360,行业内首创,技术有保证
幻影360分子悬浮消毒机属于精密设备,对消毒剂有特殊工艺要求和技术标准,只有使用专用的消毒剂和增效剂才能达到最佳的消毒效果,幻影360提供的幻影设备+增效剂+消毒机的创新无死角消毒解决方案,属于行业首创,且有着严格的实验配比和消杀实验数据做支撑,为广大用户提供切实可靠的空间消毒指导方案。
幻影360分子悬浮消毒机是众多养殖集团复养优选的空间消杀核心*器武**
可以实现猪场众多空间如办公室,仓库,宿舍,食堂,圈舍等场所的无死角消毒,高效无忧;对于消毒人员而言,执行力百分百到位,操作十分简单,放上药水,开机即用,带畜禽消毒同样如此,换对应的消毒药即可,省时省力省事,空间消毒so easy!
用过的人都说好用!